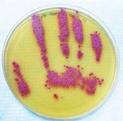

Číslo 6 / 2015
Flexibilní řešení v prevenci nozokomiálních nákaz
Studie reflektující incidenci nozokomiálních nákaz poukazují na jejich průměrný výskyt od 2,5 % do 14,8 % (Bagheri, 2011; Ahoyo, 2012). Nejvýznamnějším preventivním faktorem nozokomiálních nákaz (NN) je kombinace současných efektivních opatření (monitoring a aktivní vyhledávání jednotlivých nákaz, aseptické techniky a spolupráce klinických pracovišť s epidemiology).
Bylo prokázáno, že pokud zdravotnické zařízení provádí surveillance a kontrolu NN, dojde ke snížení NN o 32 %. V případě, že zdravotnické zařízení provádí kontrolu NN bez surveillance, dojde ke snížení NN o 6 %. V případě, že zdravotnické zařízení neprovádí kontrolu NN ani surveillance, dojde k navýšení NN o 18 %. Důsledky nozokomiálních nákaz nezhoršují jen stav pacienta (delší doba hospitalizace přináší více komplikací), ale mají významný socioekonomický dopad na zdravotnická zařízení (prodloužení délky hospitalizací, zvýšení nákladů na léčbu – obr. 1) a zdraví personálu (častější manipulace s antibiotiky). Bylo zjištěno, že NN průměrně prodlužují pobyt v nemocnici o 4 dny (Joint Comission, 2012).
V ČR je incidence NN 8–10 %. V případě, že uvážíme nozokomiální nákazu, která prodlužuje pobyt pacienta o jeden hospitalizační den, a započítáme běžné náklady, se kterými je takový pobyt ve zdravotnickém zařízení spojen (lůžko/den, plat personálu, dg vyšetření, antibiotika, materiál, prádlo), dostáváme se na částku cca 9000 Kč za jeden den (Podstatová, 2005). Významným zdrojem negativního dopadu NN jsou sami zdravotníci. Podrobnými studiemi bylo prokázáno, že 20–40 % NN je přenášeno rukama zdravotnického personálu (Bořecká, 2012), což zahrnuje zejména skupinu všeobecných sester (Sax, 2007). Z hlediska prevence nozokomiálních nákaz ošetřovatelského personálu vyhláška č. 306/2012 Sb., o podmínkách předcházení vzniku a šíření infekčních onemocnění a o hygienických požadavcích na provoz zdravotnických zařízení a ústavů sociální péče, definuje hygienické požadavky na příjem a ošetřování pacientů do zdravotnického zařízení a ústavu sociální péče. Obecně lze říci, že každý zdravotnický pracovník je povinen využít aseptické techniky před a po kontaktu s každým pacientem.
V Argentině (Rosenthal, 2005) při aplikování epidemiologických opatření (dezinfekce a mytí rukou) došlo k výraznému snížení infekcí krevního řečiště v souvislosti s intravaskulárními přístupy o 75 %. Ačkoli infekce krevního řečiště představují jen 11 % ze všech NN, jsou příčinou 1/3 všech úmrtí souvisejících s NN. Z hlediska péče o ruce rozlišujeme dvě základní metody: mechanické mytí rukou (voda a mýdlo) a hygienickou dezinfekci rukou (alkoholový preparát). V současnosti se dostává do popředí zejména druhá technika. Světová zdravotnická organizace doporučuje mechanické mytí rukou pouze v pěti případech:
- na začátku směny,
- na konci směny,
- po použití toalety,
- v případě, že jsou ruce viditelné znečištěné,
- při výskytu sporulujících forem Clostridium difficile (některé bakterie vytvářejí spory, které slouží k dlouhodobému přežití i za nepříznivých podmínek).
Ve všech ostatních případech používáme hygienickou dezinfekci rukou. Ta jediná dokáže efektivně snížit incidenci NN na rukou zdravotníků. Výsledky prokazují efekt pouze u poloviny NN, protože se vyskytují nedostatky při jejím správném používání:
- nevyčká se na zaschnutí dezinfekce (dezinfekce musí být do rukou vtírána minimálně 15 vteřin),
- hned po HDR se nasadí rukavice (pokud není dezinfekce dostatečně do rukou vtírána, naleptává rukavice),
- HDR se používá na nasazené rukavice (opět znehodnocení rukavic dezinfekcí a snížení účinnosti dezinfekce),
- ihned po HDR se ruce opláchnou vodou,
- otírání rukou do kalhot.

Je důležité také připomenout správnou techniku mytí rukou – nejdříve ruce navlhčíme, až pak na ně aplikujeme mýdlo (prevence smytí mýdla a nedostatečného odstranění povrchové mikroflóry vodou). Následně si ruce osušíme jednorázovými utěrkami. Pak by měla následovat hygienická dezinfekce rukou. Srovnání hygienické dezinfekce rukou a mýdla s vodou je patrné na obr. 2.
Po hygienické dezinfekci rukou je možné aplikovat na ruce malé množství rychle se absorbujícího krému – alkohol v dezinfekci ruce také vysušuje. Jen ruce, které jsou správně dezinfikované, jsou připraveny na výkon, který je úzce spojen s přenosem NN – příprava a aplikace infuzních roztoků.
Doporučení pro praxi
Jednou z možností, jak snížit riziko NN v souvislosti s infuzní terapií, je kromě výběru vhodného materiálu žilních katetrů také použití uzavřeného systému u infuzních lahví (safe set). Tento uzavřený systém využívá flexibilních vaků (nevyžadují zavzdušnění a tím průnik NN do infuze). Několik studií prokázalo pokles mortality pacientů v důsledku kontaminace organismu okolními patogeny v důsledku zavzdušnění infuze z okolního vzduchu. Maki a kol. (2011) provedli porovnání výskytu infekcí krevního řečiště ve čtyřech zemích (Argentina, Brazílie, Itálie, Mexiko). Při přechodu z otevřeného infuzního systému na uzavřený došlo k výraznému snížení katetrových sepsí (u otevřených infuzních linek byl výskyt infekcí 10,1 na 1000 katetrosepsí; přechodem na uzavřený systém došlo ke snížení na hodnotu 3,3 na 1000 katetrosepsí). Podobnou studii vedl i Graves a kol. (2011) v Mexiku a São Paulu. I v této studii došlo ke snížení výskytu infekcí krevního řečiště, mortality pacientů a ekonomických nákladů díky přechodu otevřeného infuzního systému na uzavřený. Uzavřený systém s sebou přináší řadu výhod – pro pacienty snížení rizika nozokomiálních infekcí, pro zdravotníky snadnou manipulaci a omezení chemické kontaminace (non-PVC vaky bez obsahu jedovatých ftalátů).
rukou (nahoře) ve srovnání
s hygienickým mytím rukou
(dole)


Na základě uvedených studií bylo zjištěno, že infuzní terapie má významný vliv na incidenci NN. Rozhodující je také materiál a vlastnosti infuzních systému. Opakovaně se však potvrzuje, že nejvýznamnějším precipitorem přenosu nozokomiálních infekcí jsou ruce zdravotníků, především všeobecných sester. Nezbývá než se uchýlit k důsledné kontrole jednoduchých (mytí rukou a hygienická dezinfekce), ale z hlediska prevence důležitých aseptických technik. I přes snahu poskytovat ve zdravotnických zařízeních nejlepší možnou péči je realitou nemocnic také úsilí ušetřit. Na konečném článku řetězce by měl být uzdravený pacient. Ten posuzuje péči pouze podle výsledku, nikoliv podle postupů. Je na nás, zda se rozhodneme jít moderní cestou a efektivními kroky prevence nozokomiálních nákaz. Bez stavebních kamenů hygieny a dezinfekce může být naše úsilí mnohdy zbytečně zdlouhavé.
Mgr. Jaroslav Pekara, Vysoká škola zdravotnická, o. p. s.
Další články v tomto čísle
- Oko za oko a svět bude slepý – Móhandás Karamčand Gándhí
- Ubránit se dá i propiskou či mobilem. Sestry ve VFN v Praze se učily jak
- Důstojný život do poslední chvíle
- Průzkum: Deset procent dialyzovaných pacientů nespolupracuje, čtvrtina trpí úzkostí
- Zkušenosti s tvarovatelným Esteemem®+
- Prevence VAP a význam respirační fyzioterapie u kriticky nemocných pacientů
- Ošetřovatelská péče u pacienta po urologické operaci na jednotce intenzivní péče
- WS Distální cílení tibiálního hřebu
- Při studiu i v praxi pomůže sestrám unikátní výkladový slovník
- Chyby a omyly ve vedení ošetřovatelské dokumentace











